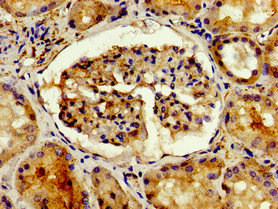

-
中文名稱:ADIPOQ兔多克隆抗體
-
貨號:CSB-PA618019YA01HU
-
規格:¥440
-
圖片:
-
Western blot
All lanes: ADIPOQ antibody at 2µg/ml
Lane 1: NIH/3T3 whole cell lysate
Lane 2: HL60 whole cell lysate
Secondary
Goat polyclonal to rabbit IgG at 1/10000 dilution
Predicted band size: 27 kDa
Observed band size: 27 kDa -
Immunohistochemistry of paraffin-embedded human kidney tissue using CSB-PA618019YA01HU at dilution of 1:100
-
-
其他:
產品詳情
-
產品名稱:Rabbit anti-Homo sapiens (Human) ADIPOQ Polyclonal antibody
-
Uniprot No.:
-
基因名:
-
別名:30 kDa adipocyte complement related protein antibody; 30 kDa adipocyte complement-related protein antibody; ACDC antibody; Acrp 30 antibody; ACRP30 antibody; ADIPO_HUMAN antibody; Adipocyte antibody; Adipocyte C1q and collagen domain containing protein antibody; Adipocyte complement related 30 kDa protein antibody; Adipocyte complement related protein of 30 kDa antibody; Adipocyte complement-related 30 kDa protein antibody; adipocyte-specific secretory protein antibody; Adiponectin antibody; Adiponectin precursor antibody; adiponectin; C1Q and collagen domain containing antibody; Adipoq antibody; Adipose most abundant gene transcript 1 antibody; Adipose most abundant gene transcript 1 protein antibody; Adipose specific collagen like factor antibody; ADIPQTL1 antibody; ADPN antibody; APM 1 antibody; apM-1 antibody; APM1 antibody; C1q and collagen domain-containing protein antibody; GBP 28 antibody; GBP28 antibody; Gelatin binding protein antibody; Gelatin binding protein 28 antibody; gelatin-binding protein 28 antibody; Gelatin-binding protein antibody; OTTHUMP00000210047 antibody
-
宿主:Rabbit
-
反應種屬:Human, Mouse
-
免疫原:Recombinant Human Adiponectin protein (19-244AA)
-
免疫原種屬:Homo sapiens (Human)
-
標記方式:Non-conjugated
本頁面中的產品,ADIPOQ Antibody (CSB-PA618019YA01HU),的標記方式是Non-conjugated。對于ADIPOQ Antibody,我們還提供其他標記。見下表:
-
克隆類型:Polyclonal
-
抗體亞型:IgG
-
純化方式:>95%, Protein G purified
-
濃度:It differs from different batches. Please contact us to confirm it.
-
保存緩沖液:Preservative: 0.03% Proclin 300
Constituents: 50% Glycerol, 0.01M PBS, PH 7.4 -
產品提供形式:Liquid
-
應用范圍:ELISA, WB, IHC
-
推薦稀釋比:
Application Recommended Dilution WB 1:500-1:5000 IHC 1:20-1:200 -
Protocols:
-
儲存條件:Upon receipt, store at -20°C or -80°C. Avoid repeated freeze.
-
貨期:Basically, we can dispatch the products out in 1-3 working days after receiving your orders. Delivery time maybe differs from different purchasing way or location, please kindly consult your local distributors for specific delivery time.
-
用途:For Research Use Only. Not for use in diagnostic or therapeutic procedures.
引用文獻
- CXCR3 confers sorafenib resistance of HCC cells through regulating metabolic alteration and AMPK pathway Y Ren,Am J Transl Res,2020
相關產品
靶點詳情
-
功能:Important adipokine involved in the control of fat metabolism and insulin sensitivity, with direct anti-diabetic, anti-atherogenic and anti-inflammatory activities. Stimulates AMPK phosphorylation and activation in the liver and the skeletal muscle, enhancing glucose utilization and fatty-acid combustion. Antagonizes TNF-alpha by negatively regulating its expression in various tissues such as liver and macrophages, and also by counteracting its effects. Inhibits endothelial NF-kappa-B signaling through a cAMP-dependent pathway. May play a role in cell growth, angiogenesis and tissue remodeling by binding and sequestering various growth factors with distinct binding affinities, depending on the type of complex, LMW, MMW or HMW.
-
基因功能參考文獻:
- Serum adiponectin correlates negatively with bone density in type 2 diabetic osteoporotic postmenopausal women. PMID: 29853264
- The 276G gene of adiponectin may be a susceptibility gene of CHD, and the genotype GG may be related to the severity of this disease. PMID: 30311881
- Alongside insulin resistance, increased sympathetic activity is associated with and may modulate HMW adiponectin levels in women with polycystic ovary syndrome. PMID: 29428305
- The adiponectin +276G/T polymorphism may be associated with the development of Kawasaki disease. PMID: 30022756
- Genetic polymorphisms in the adiponectin gene of recipients (but not donors) are associated with early de novo posttransplant hepatic steatosis. PMID: 29863454
- Expression of adiponectin inhibit the proliferation of colorectal cancer HCT116 cells and induce cell arrest at G1/G0 phase and promote apoptosis. PMID: 29773108
- Adiponectin was negatively related only in obese subjects PMID: 30070872
- ADIPOQ gene SNP rs182052 was associated with antipsychotic-induced weight gain. PMID: 28327672
- the current study indicated that the adiponectin expression levels were higher in the osteoarthritis patients than in the healthy controls. PMID: 30115130
- Serum total adiponectin and gender-specific ADIPOQ variants predict CHD and IS, but not HF, independently of other risk factors in community-based patients with T2D. PMID: 29969725
- severely obese patients, adiponectin gene expression in visceral adipose tissue (VAT) is negatively correlated with serum levels of uric acid and is an independent determinant, together with anthropometric parameters of visceral obesity and serum adiponectin levels, of insulin resistance. PMID: 29645064
- Adiponectin and colon cancer: evidence for inhibitory effects on viability and migration of human colorectal cell lines. PMID: 29446048
- Our meta-analysis suggests that the rs1501299 polymorphism may play a protective role in hypertension in Caucasian subgroup PMID: 28181566
- Studied the association of SNPs in the adiponectin gene with coronary artery disease in 277 Tunisian patients with angiographically confirmed coronary artery disease. PMID: 29633340
- Increased cardiovascular disease risk is associated with ADIPOQ SNPs, rs266729 and rs2241766, but not associated with rs1501299 (meta-analysis). PMID: 29807528
- High ADIPOQ expression is associated with hypothyroidism. PMID: 28728192
- adiponectin 45T/G polymorphism is associated with diabetic cardiovascular complication in type 2 diabetes PMID: 29686595
- preoperative adiponectin levels correlate with postoperative complications after cancer surgery PMID: 29141566
- women with gestational diabetes showed significantly low adiponectin and high resistin levels when compared with control group. PMID: 29207892
- Late improvement of low-density lipoprotein cholesterol and adiponectin after transplant suggested that kidney transplant recipients may still have risk of cardiovascular events, especially in the first years. PMID: 27267514
- Findings suggest a significant association between variants in COL13A1, ADIPOQ, SAMM50, and PNPLA3, and risk of NAFLD/elevated transaminase levels in Mexican adults with an admixed ancestry. PMID: 29307798
- fetuin a to adiponectin ratio is more strongly associated with metabolic syndrome and its components than fetuin-A or adiponectin alone PMID: 28779425
- component of mid-trimester amniotic fluid; its concentration varies with maternal body mass index and subsequent development of preterm birth, fetal growth restriction, and respiratory distress syndrome PMID: 28708576
- Data suggest that first trimester measurement of adiponectin and 1,5-anhydroglucitol are potential early serum biomarkers for later onset of gestational diabetes; both serum levels are lower in women who later develop gestational diabetes than in women who do not. This study was conducted in Dublin, Ireland. PMID: 29328940
- Worse nutritional state in de novo heart failure patients is associated with higher adiponectin plasma levels. Their levels were upregulated in adipose cells after being nutrients-starved. These results may help us to understand the adiponectin paradox in heart failure. PMID: 29559829
- Adiponectin may be considered a biomarker of metabolic compensation, inversely associated with chronic low-grade inflammation. Circulating adiponectin is also associated with lower risk of adverse cardivascular events in patients with severe carotid stenosis. PMID: 29305337
- Review/Meta-analysis: circulating adiponectin levels were significantly higher in patients with rheumatoid arthritis, but there was no correlation with disease activity. PMID: 28205390
- ADIPOQ rs1501299 gene polymorphism is associated with an increased risk of new-onset diabetes mellitus after liver transplantation. PMID: 29291779
- Serum levels of adiponectin were significantly and negatively associated with bone mineral density in patients with knee osteoarthritis. PMID: 29343264
- Data suggest that higher consumption of bread and dairy products along with low intake of rice may be associated with increased serum adiponectin in Japanese women. PMID: 28637371
- Data suggest that plasma adiponectin levels in obese women with low REE (resting energy expenditure) are significantly lower compared to obese women with low REE and compared to normal weight women. PMID: 29017362
- Elevated plasma adiponectin concentrations were associated with both clinical and radiological disease severity in knee osteoarthritis patients. PMID: 26544540
- High ADIPOQ expression is associated with osteoporosis and arterial stiffness. PMID: 28646476
- Higher adiponectin levels were associated with a more favourable development of cardiovascular autonomic function in individuals with type 2 diabetes independently of multiple confounders. PMID: 29195493
- Low ADIPOQ expression is associated with obesity. PMID: 28087246
- Findings indicate that blood adiponectin concentration is more likely to be an epiphenomenon in the context of metabolic disease than a key determinant. PMID: 29237687
- elevated circulating total adiponectin levels were associated with lower 10-year cardiovascular disease risk in adults without previous cardiovascular disease PMID: 29039145
- in lumbar facet joint osteoarthritis, expression in the subchrondral bone decreased as the degeneration increased PMID: 29100514
- Data suggest that transient increases in plasma adiponectin levels and transient decreases in plasma leptin levels occur following high-intensity interval exercise in overweight and obese young women. These studies were conducted in Turkey in formerly sedentary women ages 20-30 years. PMID: 28857629
- Adipolin and adiponectin are cytokines that exert substantial impact on obesity, progression of atherosclerosis, insulin resistance, and glucose metabolism. PMID: 29452073
- This meta-analysis demonstrates that serum/plasma levels of adiponectin in type 1 diabetes mellitus, rheumatoid arthritis, and systemic lupus erythematosus patients were higher than those in normal controls, but not in ankylosing spondylitis patients. PMID: 28702765
- Data suggest that, in overweight and obese subjects, weight reduction induces changes in chemerin serum levels in parallel with adiponectin plasma levels; chemerin is down-regulated and adiponectin is up-regulated in both insulin-resistant and insulin-sensitive subjects after weight reduction; however, only changes in chemerin in insulin-sensitive subjects were found to be statistically significant. PMID: 28323510
- ADIPOQ rs182052 AA allele is associated with obesity. PMID: 28947843
- The current investigation demonstrated that, unlike the reduction in the levels of all the adiponectin isoforms and the high molecular weight (HMW) / total adiponectin (TA) ratio, an increased low molecular weight (LMW) / TA ratio was associated with T2D through its relation to insulin resistance. PMID: 29494595
- This study showed that homeostatic model assessment (HOMA)-insulin resistance (IR) but not HOMA-adiponectin was appropriate for diagnosing IR. PMID: 29217381
- Data suggest that vitamin D deficiency (indicated by low maternal 25(OH)D concentrations) in overweight/obese pregnant women at high-risk of gestational diabetes is associated with increased cardiometabolic risk during pregnancy and with adverse pregnancy outcomes; these associations may be mediated by HMW-adiponectin. PMID: 28741856
- The depigmenting effect of adiponectin was mediated via AMPK activation, which induced the inhibitory phosphorylation of CREB-regulated transcription co-activators (CRTCs) and subsequent suppression of the novel CRTC/CREB pathway in melanocytes. PMID: 28481450
- In anorexia nervosa subjects, TT genotype in ADIPOQ c.276 polymorphism was significantly more frequent than in control group. PMID: 28759190
- Our data suggest that adiponectin and resistin are altered in non-obese chronic migraineurs. PMID: 27553954
- An increased proportion of trunk fat is associated with decreased adiponectin in relatively overweight children, and also demonstrated that girls with a normal volume of body fat that follows a more centralized distribution show decreased adiponectin. PMID: 26655234
顯示更多
收起更多
-
相關疾病:Adiponectin deficiency (ADPND); Diabetes mellitus, non-insulin-dependent (NIDDM)
-
亞細胞定位:Secreted.
-
組織特異性:Synthesized exclusively by adipocytes and secreted into plasma.
-
數據庫鏈接:
Most popular with customers
-
-
YWHAB Recombinant Monoclonal Antibody
Applications: ELISA, WB, IHC, IF, FC
Species Reactivity: Human, Mouse, Rat
-
Phospho-YAP1 (S127) Recombinant Monoclonal Antibody
Applications: ELISA, WB, IHC
Species Reactivity: Human
-
-
-
-
-